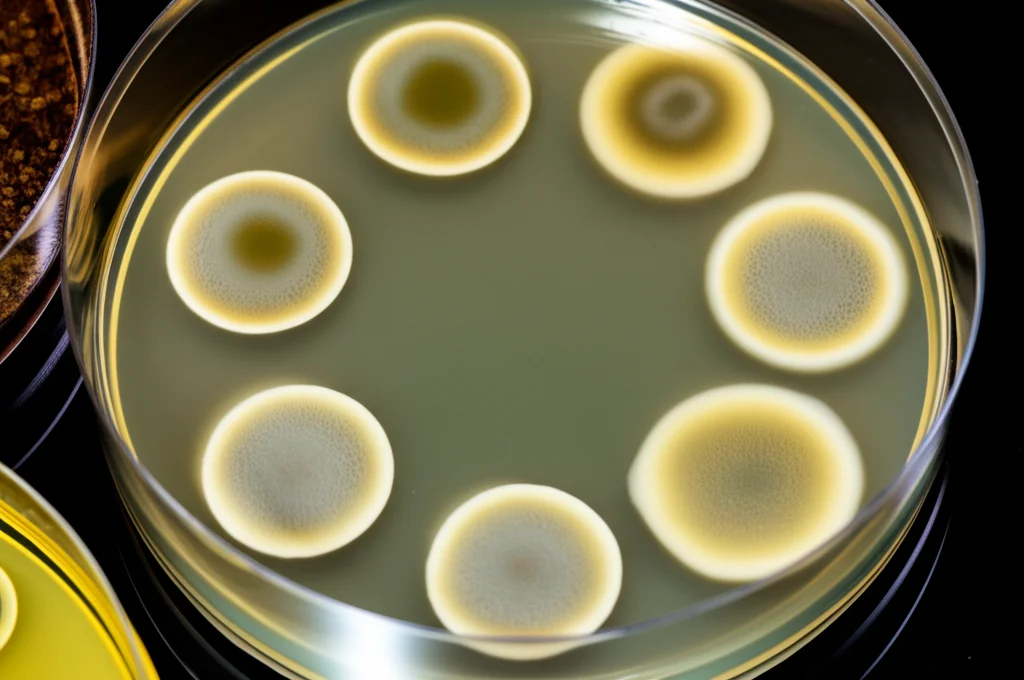
Immagine di laboratorio still life: diverse piastre Petri con colture fungine (Rhizopus e Monilinia). Alcune mostrano una crescita fungina normale (controllo), altre mostrano zone di inibizione evidenti attorno a dischetti imbevuti di estratto di Neem. Obiettivo macro 105mm, messa a fuoco precisa, illuminazione controllata da laboratorio.

Neem: Il Tuo Alleato Naturale Contro le Muffe Post-Raccolta delle Pesche!
Ciao a tutti! Oggi voglio parlarvi di un problema che, scommetto, molti di noi hanno sperimentato: comprare delle splendide pesche succose e profumate, per poi vederle tristemente coperte di muffa dopo pochi giorni. Che frustrazione, vero? E pensate che questo non è solo un fastidio domestico, ma una vera piaga a livello globale. Si stima che le perdite di frutta e verdura fresca dopo la raccolta possano arrivare addirittura al 50%, a volte anche di più se le condizioni sono “ideali” per i microbi. Anche nei paesi tecnologicamente avanzati, si parla di un buon 20% di prodotto che va perso. Un vero spreco!
I Nemici Invisibili delle Nostre Pesche
Per le nostre amate pesche, i principali colpevoli di questo disastro post-raccolta hanno nomi scientifici un po’ ostici, ma causano danni ben visibili: parlo di Rhizopus stolonifer, responsabile del marciume molle (quella muffa nerastra e un po’ pelosa, simile a quella del pane), e di Monilinia fructicola, che provoca il marciume bruno. Questi funghi sono dei veri guastafeste, capaci di rovinare interi raccolti se non si interviene. Le spore di Rhizopus, ad esempio, sono praticamente ovunque nell’aria e basta una piccola lesione sulla buccia del frutto, magari avvenuta durante la raccolta o l’imballaggio, per dare il via all’infezione.
La Soluzione Chimica? Forse Non è l’Ideale…
Certo, l’industria ha sviluppato un arsenale di fungicidi sintetici per combattere queste minacce. Ma, siamo onesti, l’idea di spruzzare prodotti chimici sulla frutta che poi mangeremo non entusiasma nessuno. E non è solo una questione di percezione: l’uso massiccio di questi prodotti solleva preoccupazioni reali. Parliamo di inquinamento ambientale, di tossicità residua sui prodotti, dello sviluppo di resistenze da parte dei funghi (che diventano sempre più difficili da eliminare) e persino di potenziali effetti cancerogeni. Insomma, forse è il caso di cercare alternative più… naturali?
La Risposta dalla Natura: L’Albero di Neem
Ed è qui che entra in gioco un protagonista inaspettato, ma potentissimo: l’albero di Neem, scientificamente noto come Azadirachta indica. Originario di India, Pakistan, Bangladesh e Nepal, questo albero è una vera e propria farmacia naturale, usata da secoli nella medicina tradizionale. Ma le sue virtù non si fermano qui. Negli ultimi anni, la scienza ha iniziato a esplorare seriamente il suo potenziale anche in agricoltura, come alleato contro insetti, parassiti e, appunto, funghi! Il Neem è ricco di composti bioattivi affascinanti, come Nimbin, Nimbidin, Nimbolide e Limonoidi, oltre a flavonoidi come la quercetina e il ß-sitosterolo, noti per le loro proprietà antibatteriche e antifungine. Pensate che oltre l’80% della popolazione mondiale fa ancora affidamento sulle piante medicinali! E il Neem è una superstar in questo campo.

La Prova del Nove: Neem contro i Funghi delle Pesche
Affascinati da queste premesse, abbiamo voluto vederci chiaro. Potevano gli estratti di Neem davvero contrastare quei fastidiosi funghi che rovinano le nostre pesche? Ci siamo messi al lavoro, preparando estratti sia dai fiori che dalle radici del Neem, utilizzando due solventi diversi: etanolo (alcol) e acqua. Volevamo capire quale parte della pianta e quale tipo di estratto funzionasse meglio. Abbiamo quindi messo alla prova questi estratti contro i nostri “nemici”, Rhizopus stolonifer e Monilinia fructicola, in laboratorio e direttamente sulle pesche. Abbiamo misurato diversi parametri:
- Inibizione della crescita del micelio: Quanto l’estratto riusciva a bloccare l’espansione della “ragnatela” fungina.
- Inibizione della germinazione delle spore: Se l’estratto impediva alle spore (i “semi” del fungo) di germogliare.
- Peso secco del micelio: Un modo per misurare quanta “massa” fungina si sviluppava.
- Diametro della lesione: Quanto si allargava la macchia di marciume sulle pesche trattate.
- Incidenza del marciume: Quante pesche trattate sviluppavano comunque il marciume.
- Severità della malattia: Quanto esteso era il danno sulle pesche infette.
Risultati Sorprendenti: Il Fiore di Neem in Etanolo Vince!
Ebbene, i risultati sono stati davvero incoraggianti! L’estratto etanolico dei fiori di Neem si è dimostrato il più potente combattente, soprattutto contro Rhizopus stolonifer. Pensate: è riuscito a inibire la germinazione delle spore dell’80% e a bloccare la crescita del micelio del 71,25%! Anche sulle pesche vere e proprie, questo estratto ha mostrato i risultati migliori, con la più bassa incidenza di marciume (solo il 18,5% contro Rhizopus dopo 7 giorni) e le lesioni più piccole (appena 0,6 cm di diametro). In generale, abbiamo osservato che:
- Gli estratti etanolici (sia di fiore che di radice) erano nettamente più efficaci di quelli acquosi. Questo suggerisce che i composti antifungini più potenti si sciolgono meglio nell’alcol che nell’acqua.
- Gli estratti di fiore tendevano a funzionare meglio di quelli di radice.
- Entrambi i funghi sono stati contrastati, ma Rhizopus stolonifer è sembrato leggermente più sensibile agli estratti rispetto a Monilinia fructicola.
Anche il peso secco del micelio era significativamente più basso quando i funghi venivano trattati con l’estratto etanolico di fiore, confermando il suo effetto “velenoso” sulla crescita fungina.
Il Segreto? Un Cocktail di Fitochimici
Ma cosa rende il Neem così efficace? Come accennato, la pianta è una miniera di sostanze chimiche naturali, i cosiddetti fitochimici. La nostra analisi ha confermato la presenza abbondante di composti come alcaloidi, fenoli, saponine, tannini, flavonoidi, terpenoidi e glicosidi, soprattutto negli estratti etanolici (in particolare quello di fiore). Ognuna di queste categorie di composti ha meccanismi d’azione diversi, ma il risultato finale è lo stesso: mettere i bastoni tra le ruote ai microrganismi patogeni. I tannini, ad esempio, sono noti per la loro tossicità verso funghi e batteri. Le saponine, con le loro proprietà simili al sapone, possono disturbare le membrane cellulari dei funghi. È questo cocktail naturale di molecole bioattive, sviluppato dalla pianta stessa come meccanismo di difesa, a conferire al Neem le sue straordinarie proprietà fungicide.
Un Futuro Più Verde per la Conservazione della Frutta?
Questi risultati sono entusiasmanti perché aprono la porta a un’alternativa concreta e sostenibile ai fungicidi di sintesi. Immaginate di poter trattare le pesche (e potenzialmente altra frutta e verdura) dopo la raccolta con un prodotto derivato da una pianta, biodegradabile, economico (il Neem cresce facilmente in molte parti del mondo) e con un profilo di sicurezza decisamente più rassicurante per noi e per l’ambiente. Certo, la ricerca deve continuare. Bisognerà condurre studi più ampi, direttamente sul campo, ottimizzare i metodi di estrazione e le formulazioni, standardizzare il contenuto dei principi attivi (come l’azadirachtina, uno dei composti più famosi del Neem) e valutare l’impatto economico su larga scala. Ma la strada sembra tracciata. L’uso di estratti botanici come quelli di Neem potrebbe davvero rivoluzionare il modo in cui proteggiamo i nostri raccolti, riducendo le perdite e offrendoci cibo più sano e sicuro. È una prospettiva affascinante, non trovate? Il Neem ci dimostra ancora una volta quanto abbiamo da imparare dalla saggezza della Natura.
Fonte: Springer
